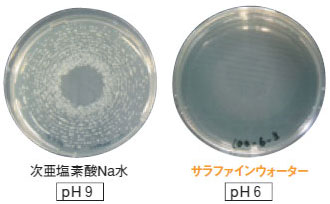

- ホーム
- 製品詳細
製品詳細
- (株)タクミナ
-
【所在地】〒541-0047大阪府大阪市中央区淡路町2-2-14北浜グランドビル10F
【電話番号】06-6208-3971 【FAX番号】06-6208-3978
![]() |
![]() |
![]() |
サラファインウォーターとは |
![]() |
サラファインウォーターの殺菌力 |
![]() |
サラファインウォーターの安全性 |
![]() |
サラファインウォーターの殺菌スペクトル |
![]() |
サラファインウォーターの用途 |
![]() |
殺菌装置・機器 製品ラインナップ |
サラファインウォーターとは |
| 独自のpH制御技術で次亜塩素酸ナトリウム水を弱酸性にコントロール。 高い殺菌力を持った次亜水が、タクミナのサラファインウォーターです。 |
| pH値が殺菌力を左右します。 | |
![]() |
| 【有効塩素とpH値の関係】 | |
![]() |
サラファインウォーターの殺菌力 |
| 弱酸性次亜水の実証実験 |
| 【芽胞(セレウス菌・枯草菌)の場合】 | |
![]() |
| 【黄色ブドウ球菌(タンパク質添加)の場合】 黄色ブドウ球菌の菌液に100mg/L(水温20℃)の次亜塩素酸Na水とサラファインウォーターをそれぞれ添加し3分後の変化を調べた結果、高い殺菌効果が得られました。 |
|
![]() |
|
| *実際の洗浄現場に近い状況にするため、試料にタンパク質を添加しています。 |
サラファインウォーターの安全性 |
| 【生体への影響(動物試験)】 各種試験により、安全性を確認しています。 |
|
![]() |
サラファインウォーターの殺菌スペクトル |
| 【代表的消毒剤との殺菌スペクトルの比較】 | |
![]() |
サラファインウォーターの用途 |
|
| ● | 飲食店(レストラン)、スーパー、ホテル・旅館、オフィスビル 等各種施設 | |
| 壁・床(フローリング)・浴室(浴槽)・トイレ、 厨房・調理台・まな板・食器・食品トレー・ふきん、食材(生鮮食品・野菜) |
||
| ● | 医療施設(病院・歯科・クリニック)、介護施設、福祉施設 等各種施設 | |
| 壁・床(フローリング)・器具・浴室(浴槽)・トイレ、 ガーゼ・車イス、口腔ケア、傷、やけど、水虫、床ずれ |
||
| ● | 食品工場(食肉加工・水産加工)、飲料工場(乳業・ビール)、給食・ケータリング | |
| 壁・床(フローリング)、コンベア・配管、機器、 ペットボトル・紙パック、食材、作業着・長靴 |
||
| ● | 農業、酪農 | |
| 農作物、搾乳機 |
|
| ◆殺菌装置・機器 製品ラインナップ |
| 弱酸性次亜水生成装置 | |||||||||||
![]() |
|
||||||||||
![]() |
|
||||||||||
| ◆タクミナの製品ラインナップ |